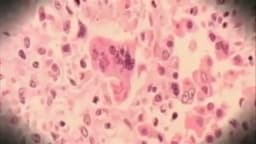
article image

Home / Health / Measles Alert at Denver Airport
Measles Alert at Denver Airport
24 Dec
Summary
- Measles exposure possible at Denver International Airport on Dec. 12.
- An out-of-state traveler with measles was at the airport.
- Vaccination is the best protection against the highly contagious disease.

Health officials have issued a warning to travelers concerning a potential measles exposure at Denver International Airport. The incident occurred on December 12, when an out-of-state traveler, confirmed to have measles, passed through the airport while infectious. Exposure is possible for passengers who were in Concourse B between 7:24 p.m. and 9:41 p.m. on that date, specifically near gates B45 and B84.
Individuals identified as potentially exposed will be directly contacted by state or local public health departments. Although the infected traveler was vaccinated and experienced mild symptoms, which lowers the transmission risk, measles is known to be highly contagious. Health authorities emphasize that measles is a vaccine-preventable illness.
Measles symptoms include fever, cough, runny nose, and red eyes, followed by a distinctive rash. The most effective way to prevent measles is through vaccination with the measles, mumps, and rubella (MMR) vaccine, protecting individuals and the community. Those who may have been exposed are advised to monitor for symptoms for 21 days and contact a healthcare provider before visiting if symptoms appear.